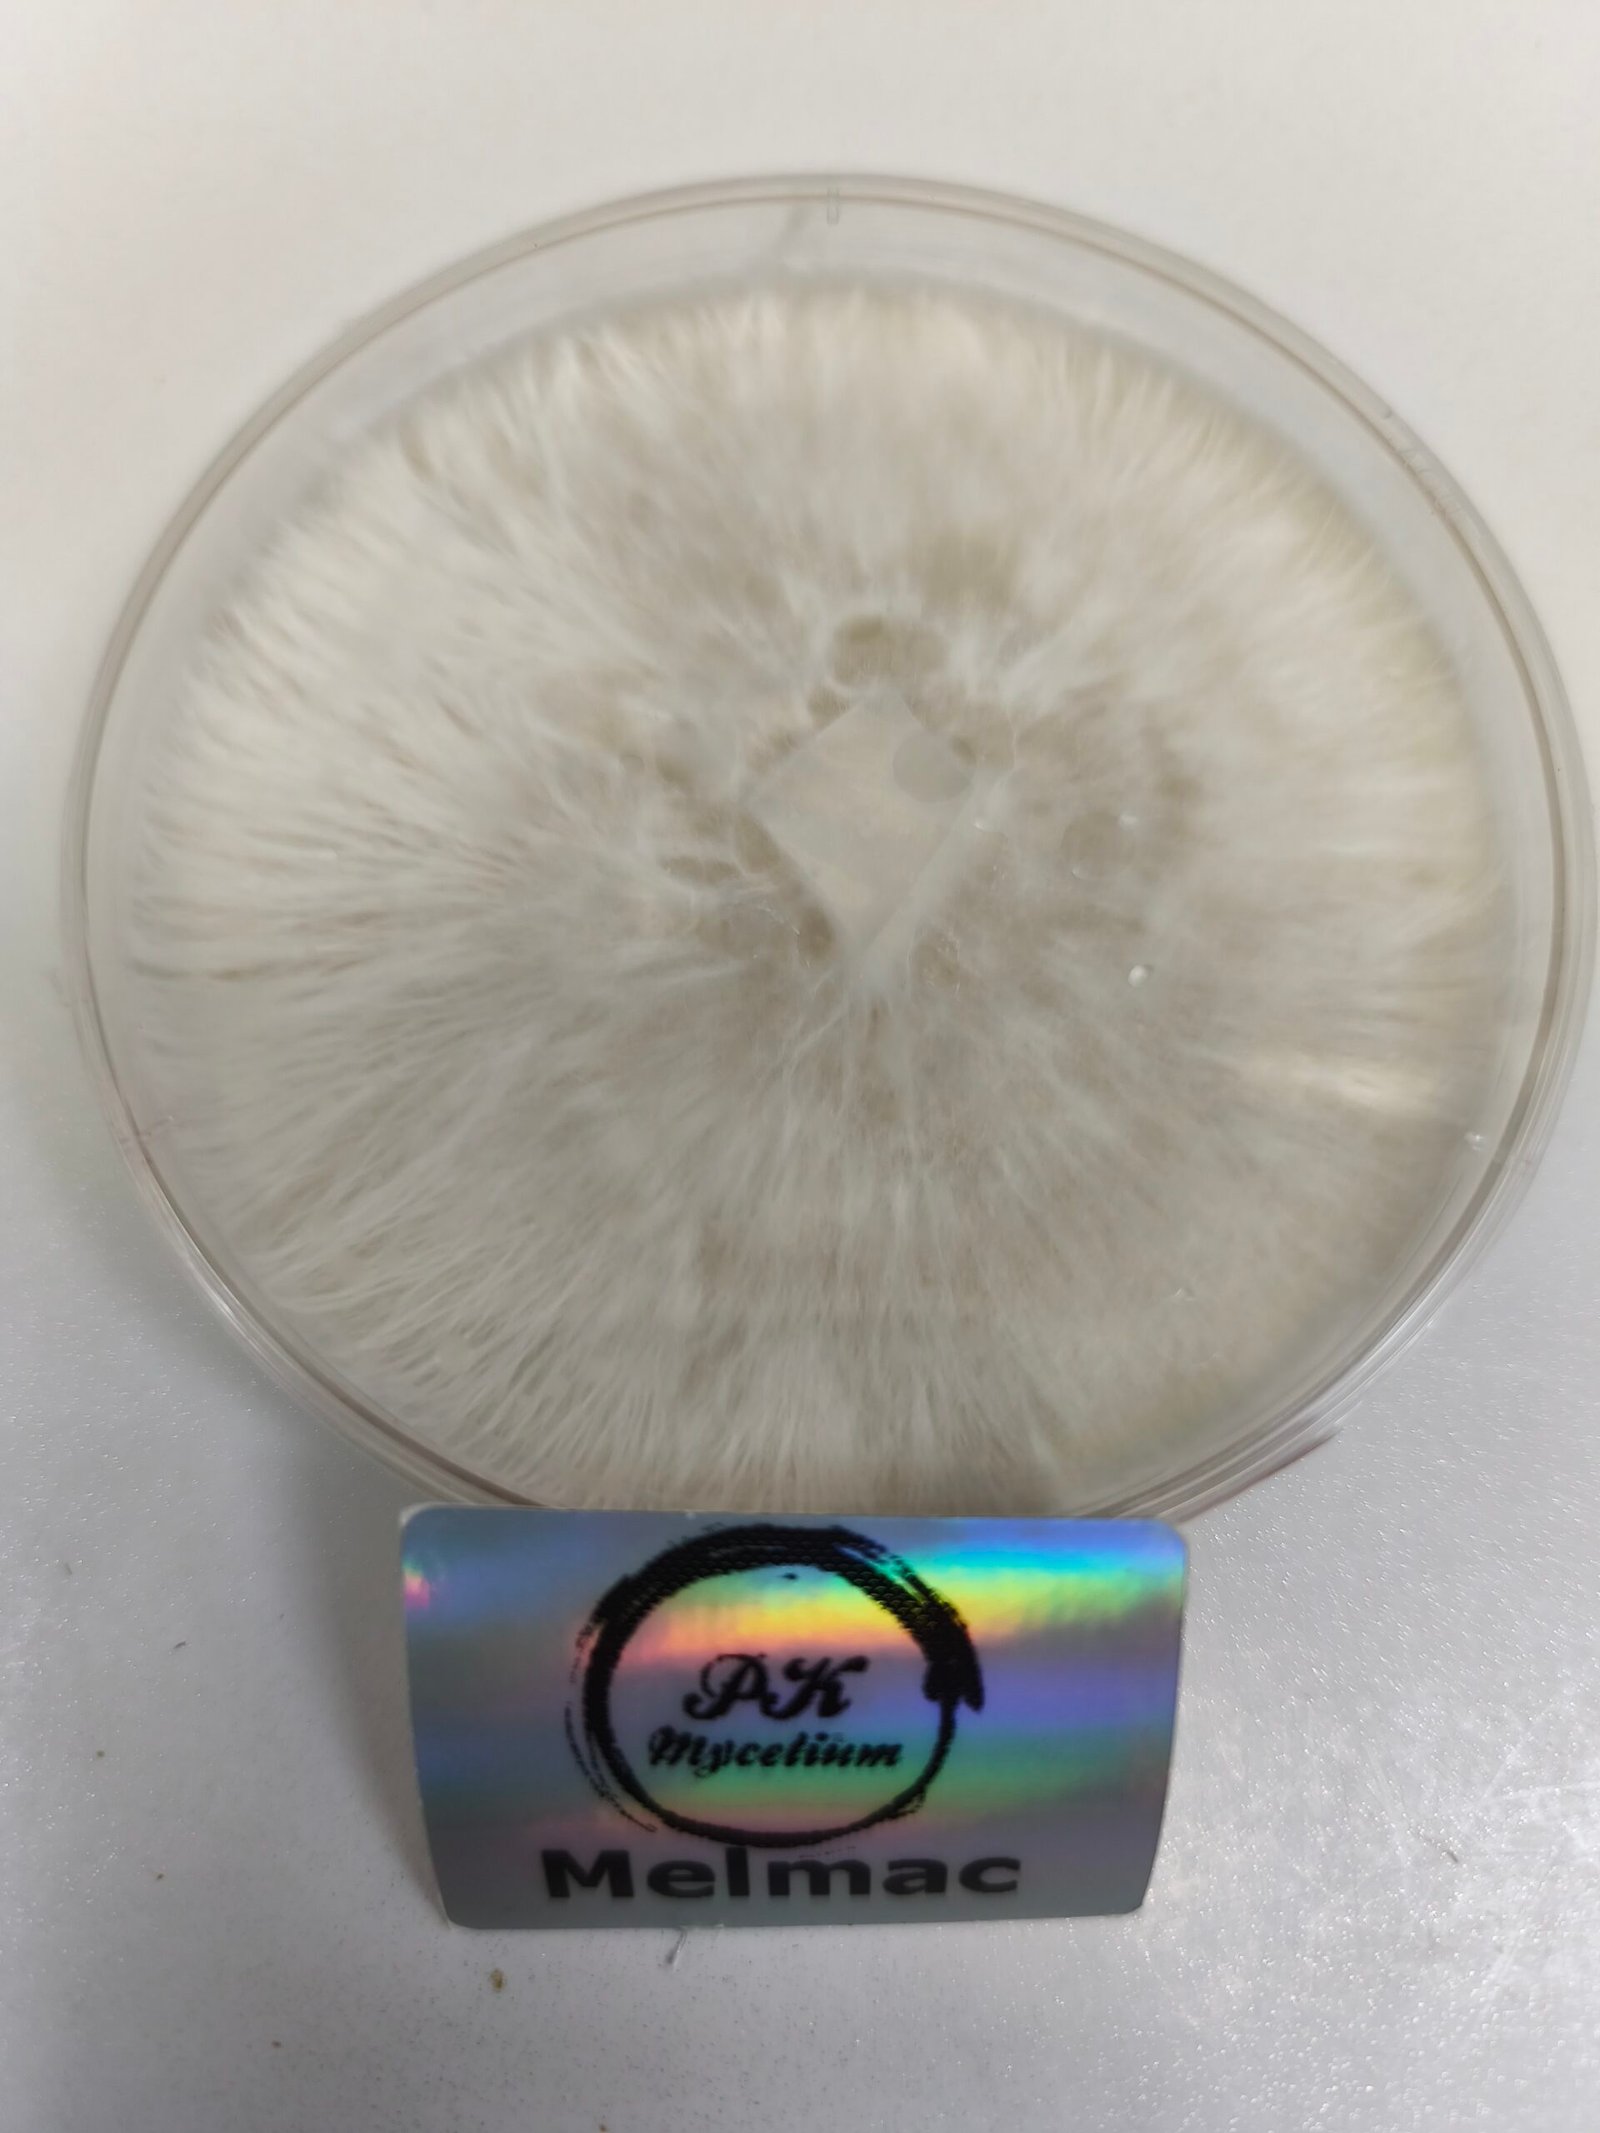

La Placa Petri de Melmac es el punto de partida ideal para trabajar con esta cepa a nivel de laboratorio. Perfecta para aislamientos, expansión de micelio y conservación genética de alta pureza.
Melmac
Potencia Bruta y Morfología Extrema en un Linaje Penis Envy
Origen y Características Históricas
Creador y linaje:
Melmac — también conocida como Homestead Penis Envy — es una variante de Psilocybe cubensis del linaje Penis Envy, aislada por Rich Gee mientras trabajaba para la Homestead Book Company en el Noroeste de EE.UU. durante los años 80. Las esporas originales provinieron del material amazónico de Terence McKenna. Gee observó una mutación donde el sombrero no se erguía y los primordios fallaban frecuentemente — ese aislamiento fue Melmac. Su morfología de tallos retorcidos, caps doradas onduladas y aspecto alienígena inspiró el nombre: referencia al planeta Melmac del sitcom ALF (1986–1990).
Posición dentro del linaje PE:
Considerada por muchos micólogos la variante más cercana al PE original de los 70s. Su pedigree directo con la Homestead Book Company la convierte en una pieza histórica del cultivo de cubensis.
Difusión y reconocimiento:
Prácticamente desaparecida tras el cierre de Homestead, Melmac resurgió en la comunidad micológica moderna como cepa de coleccionista. Su rareza — escasa producción de esporas (~5%) — la hace difícil de obtener y muy valorada.
Importancia cultural:
Melmac es una «cepa de respeto» dentro de la comunidad psicodélica. Su vinculación con el legado de McKenna, su morfología alienígena y su potencia extrema la han convertido en objeto de culto entre psiconautas y cultivadores avanzados.
Cultivo y Rendimiento
Dificultad:
Avanzada — no recomendada para principiantes.
Condiciones recomendadas:
- Colonización: 23–25 °C
- Fructificación: 20–23 °C
- Humedad: 90–95 %
- Ventilación: muy controlada
- Luz: indirecta
- Sustratos: granos + bulk nutritivo; monotub recomendado
Rendimiento:
Medio en número de frutos pero muy alto en biomasa por ejemplar — algunos especímenes superan los 100 g en fresco («100 club»). Producción de esporas muy escasa (~5%). Ciclo de crecimiento largo: hasta 6–7 semanas para madurez completa.
Potencia y Efectos
Potencia:
Muy alta — hasta un 50% más de psilocibina que la media de Psilocybe cubensis. Reducir la dosis estándar entre un 30–50 %.
Efectos típicos:
- Visuales muy intensos y envolventes
- Distorsión profunda del ego
- Sinestesia frecuentemente reportada
- Experiencias filosóficas y existenciales
- Sensación de disolución del yo
- Viajes largos, profundos y emocionalmente demandantes
No es una cepa recreativa. Su perfil es serio, introspectivo y a menudo desafiante.
Advertencias y Dosis Sugerida
- Reducir la dosis estándar de cubensis un 30–50 %. Empezar con 0,5–1 g para usuarios sin experiencia con PE.
- No combinar con alcohol ni fármacos incompatibles. Especial precaución con ISRSs y medicación activa.
- Recomendada exclusivamente para usuarios experimentados. No apta para primeras experiencias ni entornos no controlados.
- Siempre con acompañante de confianza o guía experimentado. Duración puede superar las 6 horas.
Aplicaciones Terapéuticas y Uso
- Sesiones de introspección profunda en entornos controlados con intención clara.
- Trabajo terapéutico avanzado: procesamiento de trauma, disolución del ego, exploración existencial.
- No recomendada para microdosis salvo con dosificación muy precisa dada su altísima potencia.
Métodos de Consumo y Preparación
- Té de psilocibina: altamente recomendado para reducir náusea y facilitar dosificación controlada.
- Lemon Tek: usar con extrema cautela — la potencia ya elevada se amplifica significativamente. Reducir dosis un 30 % adicional.
- Ingestión seca: solo para usuarios que conocen bien su tolerancia al PE.
Plano Espiritual
En el plano espiritual, Melmac es una de las cepas más transformadoras del catálogo de cubensis. Sus experiencias se caracterizan por una disolución profunda del sentido del yo, acceso a estados de conciencia expandida y visiones de alta intensidad filosófica y existencial. La sinestesia — fusión de sentidos — es un efecto reportado frecuentemente. Es la cepa de quienes buscan ir más allá de los límites habituales de la experiencia psicodélica.
Plano Terapéutico y Emocional
A nivel terapéutico y emocional, Melmac exige respeto y preparación. Su alta potencia puede desencadenar tanto experiencias profundamente sanadoras como momentos de intenso desafío emocional. En contextos terapéuticos avanzados y con apoyo profesional, su capacidad de inducir disolución del ego la posiciona para trabajo con traumas profundos y exploración existencial guiada.
Advertencias y Perfil de Usuario
Exclusivamente para psiconautas experimentados con conocimiento previo del linaje PE. No apta para principiantes bajo ninguna circunstancia. Requiere entorno controlado, set & setting cuidadosamente preparado y acompañante de confianza. La dosificación errónea puede resultar en experiencias abrumadoras difíciles de gestionar.
Impacto Cultural
Melmac forma parte de la historia fundacional del cultivo de cubensis de alta potencia. Su origen en la Homestead Book Company, su vinculación directa con el legado de Terence McKenna y su resurgimiento en el renacimiento psicodélico moderno la convierten en una pieza viva de la historia micológica underground. El nombre ALF no es casualidad: su aspecto alienígena y sus efectos fuera de lo ordinario la hacen merecedora del apodo.
Ventajas y Limitaciones
Ventajas:
Potencia extrema, experiencias profundas y transformadoras, biomasa muy densa, especímenes de gran tamaño, linaje histórico PE de primer orden, morfología alienígena inconfundible.
Limitaciones:
Cultivo exigente y avanzado. Producción irregular y muy escasa de esporas. Difícil de conseguir. Dosificación delicada. No apta para principiantes.
Conclusión
Melmac es una de las expresiones más intensas y crudas del linaje Penis Envy. Aislada por Rich Gee para la Homestead Book Company en los años 80, su potencia extrema, morfología alienígena y efectos profundamente transformadores la convierten en una cepa reservada para exploradores mentales avanzados. No es para todos — es para quienes están listos para ir más lejos.
🌍 Valor educativo y cultural
Estos productos son una herramienta útil para entender mejor la ecología de los hongos y su papel en la naturaleza, además de conectar con una tradición etnomicológica que ha acompañado a distintas culturas a lo largo de la historia.
⚠️ Nota importante
El uso de estos productos debe hacerse siempre dentro del marco legal de cada país y con un enfoque educativo y de observación micológica.
Comparativa Final: Melmac frente a otras cepas del linaje PE y cubensis destacadas
Característica
Melmac
APE
PE Original
Jack Frost
Avalanche
Golden Teacher
Origen
Homestead Book Co. (Rich Gee, años 80)
Mutación albina de PE
Amazónico (McKenna / Gee)
TAT × APE (Dave Wombat)
Yeti × Melmac (Wumbo Myco)
Clásica de los 80
Potencia
Muy alta (+50% media cubensis)
Muy alta
Muy alta
Alta
Alta
Media-alta
Efectos
Disolución ego, sinestesia, filosófico
Profundos, visionarios
Intensos, introspectivos
Visuales intensos, meditativo
Visuales, claridad
Equilibrado, introspectivo
Morfología
Tallos retorcidos, caps doradas onduladas
Albina, caps blancas-azuladas
Fálica clásica, cap cerrada
Albino, branquias azules
Tallos blancos, caps doradas
Sombrero dorado clásico
Cultivo
Avanzado
Avanzado
Avanzado
Intermedio
Intermedio
Baja
Esporas
Muy escasas (~5%)
Escasas
Escasas
Blancas
Normal
Abundantes
Uso ideal
Expertos / ceremonial profundo
Expertos
Expertos
Experiencia previa
Experiencia básica+
Iniciación
Melmac
Potencia Bruta y Morfología Extrema en un Linaje Penis Envy
Origen y Características Históricas
Creador y linaje:
Melmac — también conocida como Homestead Penis Envy — es una variante de Psilocybe cubensis del linaje Penis Envy, aislada por Rich Gee mientras trabajaba para la Homestead Book Company en el Noroeste de EE.UU. durante los años 80. Las esporas originales provinieron del material amazónico de Terence McKenna. Gee observó una mutación donde el sombrero no se erguía y los primordios fallaban frecuentemente — ese aislamiento fue Melmac. Su morfología de tallos retorcidos, caps doradas onduladas y aspecto alienígena inspiró el nombre: referencia al planeta Melmac del sitcom ALF (1986–1990).
Posición dentro del linaje PE:
Considerada por muchos micólogos la variante más cercana al PE original de los 70s. Su pedigree directo con la Homestead Book Company la convierte en una pieza histórica del cultivo de cubensis.
Difusión y reconocimiento:
Prácticamente desaparecida tras el cierre de Homestead, Melmac resurgió en la comunidad micológica moderna como cepa de coleccionista. Su rareza — escasa producción de esporas (~5%) — la hace difícil de obtener y muy valorada.
Importancia cultural:
Melmac es una «cepa de respeto» dentro de la comunidad psicodélica. Su vinculación con el legado de McKenna, su morfología alienígena y su potencia extrema la han convertido en objeto de culto entre psiconautas y cultivadores avanzados.
Cultivo y Rendimiento
Dificultad:
Avanzada — no recomendada para principiantes.
Condiciones recomendadas:
- Colonización: 23–25 °C
- Fructificación: 20–23 °C
- Humedad: 90–95 %
- Ventilación: muy controlada
- Luz: indirecta
- Sustratos: granos + bulk nutritivo; monotub recomendado
Rendimiento:
Medio en número de frutos pero muy alto en biomasa por ejemplar — algunos especímenes superan los 100 g en fresco («100 club»). Producción de esporas muy escasa (~5%). Ciclo de crecimiento largo: hasta 6–7 semanas para madurez completa.
Potencia y Efectos
Potencia:
Muy alta — hasta un 50% más de psilocibina que la media de Psilocybe cubensis. Reducir la dosis estándar entre un 30–50 %.
Efectos típicos:
- Visuales muy intensos y envolventes
- Distorsión profunda del ego
- Sinestesia frecuentemente reportada
- Experiencias filosóficas y existenciales
- Sensación de disolución del yo
- Viajes largos, profundos y emocionalmente demandantes
No es una cepa recreativa. Su perfil es serio, introspectivo y a menudo desafiante.
Advertencias y Dosis Sugerida
- Reducir la dosis estándar de cubensis un 30–50 %. Empezar con 0,5–1 g para usuarios sin experiencia con PE.
- No combinar con alcohol ni fármacos incompatibles. Especial precaución con ISRSs y medicación activa.
- Recomendada exclusivamente para usuarios experimentados. No apta para primeras experiencias ni entornos no controlados.
- Siempre con acompañante de confianza o guía experimentado. Duración puede superar las 6 horas.
Aplicaciones Terapéuticas y Uso
- Sesiones de introspección profunda en entornos controlados con intención clara.
- Trabajo terapéutico avanzado: procesamiento de trauma, disolución del ego, exploración existencial.
- No recomendada para microdosis salvo con dosificación muy precisa dada su altísima potencia.
Métodos de Consumo y Preparación
- Té de psilocibina: altamente recomendado para reducir náusea y facilitar dosificación controlada.
- Lemon Tek: usar con extrema cautela — la potencia ya elevada se amplifica significativamente. Reducir dosis un 30 % adicional.
- Ingestión seca: solo para usuarios que conocen bien su tolerancia al PE.
Plano Espiritual
En el plano espiritual, Melmac es una de las cepas más transformadoras del catálogo de cubensis. Sus experiencias se caracterizan por una disolución profunda del sentido del yo, acceso a estados de conciencia expandida y visiones de alta intensidad filosófica y existencial. La sinestesia — fusión de sentidos — es un efecto reportado frecuentemente. Es la cepa de quienes buscan ir más allá de los límites habituales de la experiencia psicodélica.
Plano Terapéutico y Emocional
A nivel terapéutico y emocional, Melmac exige respeto y preparación. Su alta potencia puede desencadenar tanto experiencias profundamente sanadoras como momentos de intenso desafío emocional. En contextos terapéuticos avanzados y con apoyo profesional, su capacidad de inducir disolución del ego la posiciona para trabajo con traumas profundos y exploración existencial guiada.
Advertencias y Perfil de Usuario
Exclusivamente para psiconautas experimentados con conocimiento previo del linaje PE. No apta para principiantes bajo ninguna circunstancia. Requiere entorno controlado, set & setting cuidadosamente preparado y acompañante de confianza. La dosificación errónea puede resultar en experiencias abrumadoras difíciles de gestionar.
Impacto Cultural
Melmac forma parte de la historia fundacional del cultivo de cubensis de alta potencia. Su origen en la Homestead Book Company, su vinculación directa con el legado de Terence McKenna y su resurgimiento en el renacimiento psicodélico moderno la convierten en una pieza viva de la historia micológica underground. El nombre ALF no es casualidad: su aspecto alienígena y sus efectos fuera de lo ordinario la hacen merecedora del apodo.
Ventajas y Limitaciones
Ventajas:
Potencia extrema, experiencias profundas y transformadoras, biomasa muy densa, especímenes de gran tamaño, linaje histórico PE de primer orden, morfología alienígena inconfundible.
Limitaciones:
Cultivo exigente y avanzado. Producción irregular y muy escasa de esporas. Difícil de conseguir. Dosificación delicada. No apta para principiantes.
Conclusión
Melmac es una de las expresiones más intensas y crudas del linaje Penis Envy. Aislada por Rich Gee para la Homestead Book Company en los años 80, su potencia extrema, morfología alienígena y efectos profundamente transformadores la convierten en una cepa reservada para exploradores mentales avanzados. No es para todos — es para quienes están listos para ir más lejos.
🌍 Valor educativo y cultural
Estos productos son una herramienta útil para entender mejor la ecología de los hongos y su papel en la naturaleza, además de conectar con una tradición etnomicológica que ha acompañado a distintas culturas a lo largo de la historia.
⚠️ Nota importante
El uso de estos productos debe hacerse siempre dentro del marco legal de cada país y con un enfoque educativo y de observación micológica.
Comparativa Final: Melmac frente a otras cepas del linaje PE y cubensis destacadas
| Característica | Melmac | APE | PE Original | Jack Frost | Avalanche | Golden Teacher |
|---|---|---|---|---|---|---|
| Origen | Homestead Book Co. (Rich Gee, años 80) | Mutación albina de PE | Amazónico (McKenna / Gee) | TAT × APE (Dave Wombat) | Yeti × Melmac (Wumbo Myco) | Clásica de los 80 |
| Potencia | Muy alta (+50% media cubensis) | Muy alta | Muy alta | Alta | Alta | Media-alta |
| Efectos | Disolución ego, sinestesia, filosófico | Profundos, visionarios | Intensos, introspectivos | Visuales intensos, meditativo | Visuales, claridad | Equilibrado, introspectivo |
| Morfología | Tallos retorcidos, caps doradas onduladas | Albina, caps blancas-azuladas | Fálica clásica, cap cerrada | Albino, branquias azules | Tallos blancos, caps doradas | Sombrero dorado clásico |
| Cultivo | Avanzado | Avanzado | Avanzado | Intermedio | Intermedio | Baja |
| Esporas | Muy escasas (~5%) | Escasas | Escasas | Blancas | Normal | Abundantes |
| Uso ideal | Expertos / ceremonial profundo | Expertos | Expertos | Experiencia previa | Experiencia básica+ | Iniciación |

Valoraciones
No hay valoraciones aún.